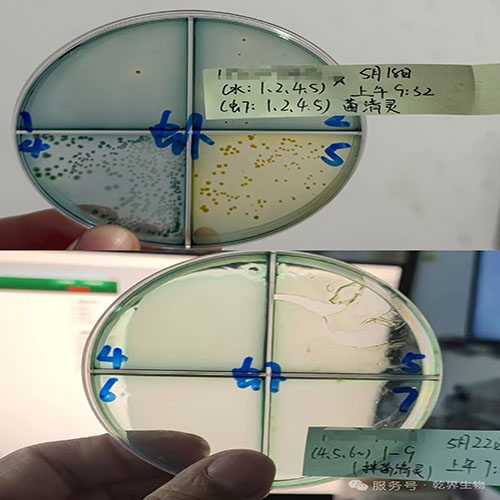

在水产养殖圈,弧菌堪称养殖户的“心腹大患”!这种微生物在高温闷热、水质恶化时会如“瘟疫”般迅速蔓延,不仅直接侵害水产动物,引发肠炎、败血症等疾病,还会破坏水体生态平衡,让养殖风险直线上升。一旦爆发,对虾偷死、贝类消瘦、鱼苗烂鳃等问题接踵而至,给养殖户带来巨大经济损失。
弧菌中**常见且危害比较大的是副溶血弧菌(绿弧菌)和哈维氏弧菌(发光弧菌)。它们会导致水产动物出现空肠空胃、肝胰腺萎缩、白便等症状,严重时会造成大面积死亡。传统防治方法往往难以精细打击弧菌,还可能破坏水体中的有益菌群,影响养殖生态平衡。
乾界菌清灵:靶向灭弧的创新解决方案
面对弧菌难题,乾界生物菌清灵凭借独特的微生物配方,为水产养殖提供了高效解决方案。这款产品对副溶血弧菌和哈维氏弧菌有***,其防治效果可通过弧菌测试剂盒进行直观检验。无论是虾、蟹还是其他水产动物,因弧菌***引起的死亡问题都能得到有效控制。
菌清灵通过外泼和内服相结合的方式,能同时抑杀水体及水产动物体内的弧菌。对于已经出现空肠空胃、肝胰腺萎缩、肠炎、白便等症状的水产动物,只要仍能吃料,使用菌清灵后便能逐渐恢复健康;未染病的水产动物则能保持健康状态,有效预防弧菌***。

四大**优势,铸就防治利器
乾界菌清灵之所以能在众多弧菌防治产品中脱颖而出,源于其四大**优势:
靶向灭弧,精细打击。菌清灵能够精细识别弧菌并裂解其细胞壁,从而达到杀灭弧菌的目的。同时,它不会伤害水体中的有益菌群,有效维护了水体生态稳定。
快速见效,持久控菌。使用菌清灵后,24小时内就能***降低弧菌浓度,3天基本***弧菌。更重要的是,它能在水体中形成有益菌保护膜,有效阻断弧菌再生,长期控制弧菌数量。
绿色安全,零残留。作为纯微生物制剂,菌清灵不含任何化学添加,符合生态养殖需求。使用后不会在水体和水产品中留下残留,保障了水产品的质量安全。
适用***,操作简便。无论是鱼、虾、蟹还是贝类等各类养殖品种,菌清灵都能发挥良好效果。操作也十分简单,只需全池泼洒或拌料使用,无需复杂的专业设备和技术。
真实案例见证:3天弧菌清零,对虾活力焕发
山东一位养殖用户的塘口曾遭遇弧菌超标问题,导致对虾吃料减少、出现空肠空胃症状,生长受到严重影响。在使用菌清灵拌料3-4天后,塘口弧菌数量实现清零,对虾活力明显恢复,吃料量也回到正常水平。这一案例充分证明了菌清灵在实际养殖环境中的优异表现。
面对弧菌这一水产养殖的“心腹大患”,乾界菌清灵凭借其高效、安全、便捷的特点,为广大养殖户提供了可靠的解决方案。无论是日常预防还是弧菌爆发时的紧急处理,它都能发挥重要作用,帮助养殖户降低风险,提高养殖效益,守护水产养殖的健康发展。
联系人:
联系手机:
联系电话:
经营模式:
所在地区:
主营项目: